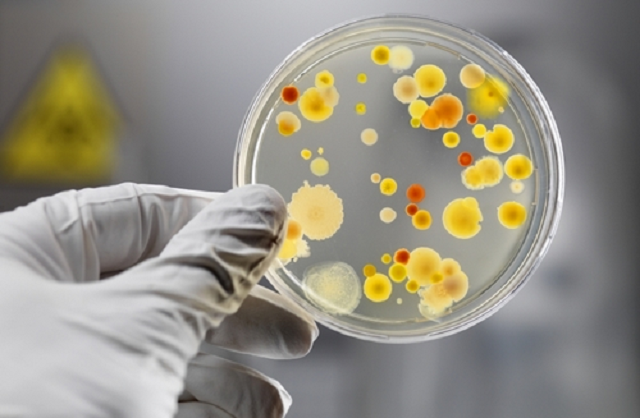
Детей увозят в больницы: туристы рассказали об эпидемии в Турции

Детей увозят в больницы: туристы рассказали об эпидемии в Турции
Детей увозят в больницы: туристы рассказали об эпидемии в Турции
В Турции дети заражаются вирусом Коксаки, что уже превратилось в стране в целую эпидемию.
Сообщает портал АНТИКОР со ссылкой на СМИ.
Об этом рассказала гражданка Молдовы Дарья Петрушина, ребенок которой также заразился.
"Дорогие мамы! Вчера мы вернулись из Турции. У ребенка вирус Коксаки. Каждый день видела, как из отеля в больницу увозят детей с температурой, инфекцией, в том числе ротавирусом. Это проблема не единственной гостиницы, а общая. Там сейчас эпидемия, - рассказала женщина.
Отметим, что вирус Коксаки входит в группу из 30 активных энтеровирусов, которые размножаются в желудочно-кишечном тракте ребенка. Его симптомы могут быть разными - от красных волдырей на коже до повышения температуры до кашля, рвоты, болей в желудке.
Инфекция попадает в организм через рот.
Это детская болезнь, переболев которой дети получают иммунитет.
Теги: ЭпидемияВирус КоксакиТурцияБолезниИнфекцииДетиТуристы
Коментарі:
comments powered by DisqusЗагрузка...
Наші опитування
Показати результати опитування
Показати всі опитування на сайті
